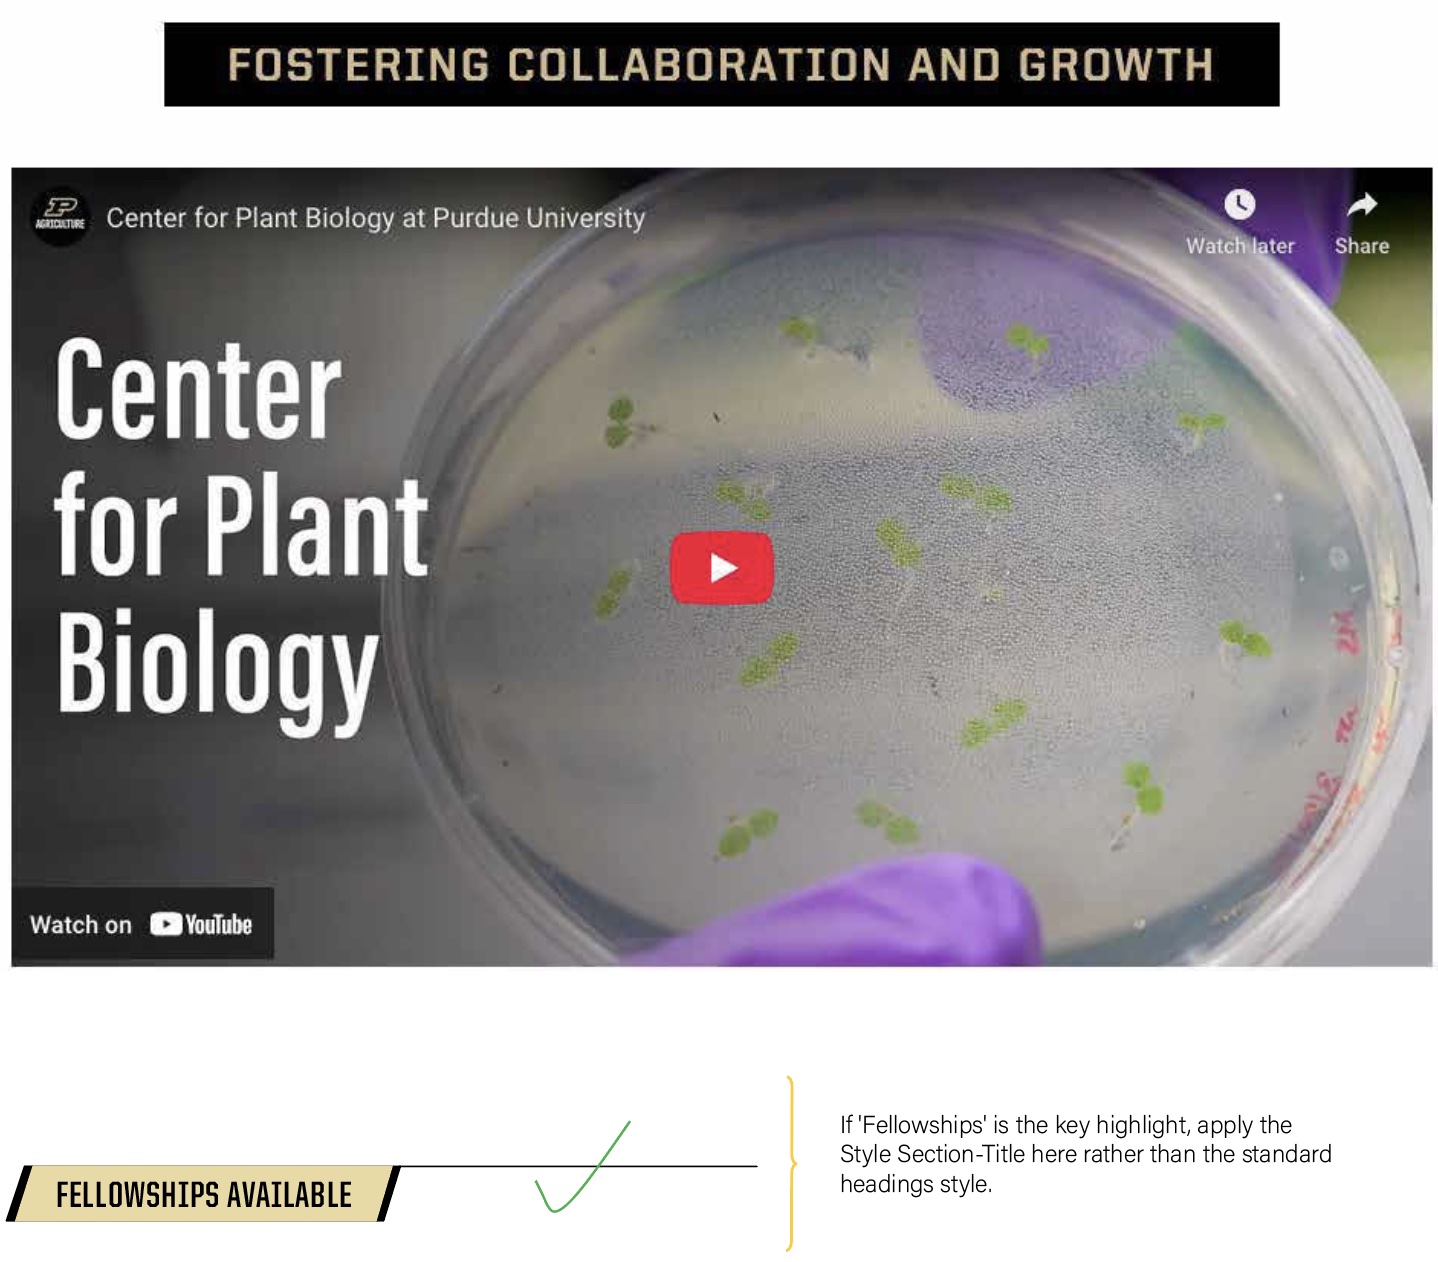
Section title example 2

Section Title Styles
Enhance your content with our new Section Title Styles, now available in the WYSIWYG editor. These styles help visually format your content, improve readability, and bring more visual interest to your page, making it more engaging for users.
Available Section Title Styles
- Eyebrow Background Black
- Eyebrow Background Gold
- Pennant Background Black
- Pennant Background Boilermaker Gold
You can easily apply these styles by selecting them directly in the WYSIWYG editor (select the title or text portion, then go to Format--> Custom and from the drop-down select the style you want to apply)

WHEN AND WHERE TO USE THEM
- They can be used when you want to emphasize the importance of an event, content, or material that follows.
- It is especially effective when prompting the user to take an action.
- You want to use these titles to call special attention to a section.
- Use only one section title per page. Section titles are not meant for organizing content; use headings for that purpose instead.
- If you are organizing your content in columns and you want to use these section titles, use them only if you are using two or three columns.
Headings are used to identify and organize content in a clear, structural hierarchy. In contrast, Section Titles are primarily used to draw attention or visually stylize specific parts of the page for emphasis or design purposes.
Examples and recommendations
This is an example of how to work with section titles
Heading here
Li Europan lingues es membres del sam familie. Lor separat existentie es un myth. Por scientie, musica, sport etc, litot Europa usa li sam vocabular. Li lingues differe solmen in li grammatica, li pronunciation e li plu commun vocabules. Omnicos directe al desirabilite de un nov lingua franca: On refusa continuar payar custosi traductores. At solmen va esser necessi far uniform grammatica, pronunciation e plu sommun paroles. Ma quande lingues coalesce, li grammatica del resultant lingue es plu simplic e regulari quam ti del coalescent lingues. Li nov lingua franca va esser plu simplic e regulari quam li existent Europan lingues. It va esser tam simplic quam Occidental in fact, it va esser Occidental. A un Angleso it va semblar un simplificat Angles, quam un skeptic Cambridge amico dit me que Occidental es.

More content here...
Fellowships are merit-based awards of funding for training, travel, and tuition. They might provide a trainee with a greater salary...
More content...
Li Europan lingues es membres del sam familie. Lor separat existentie es un myth. Por scientie, musica, sport etc, litot Europa usa li sam vocabular. Li lingues differe solmen in li grammatica, li pronunciation e li plu commun vocabules. Omnicos directe al desirabilite de un nov lingua franca: On refusa continuar payar custosi traductores. At solmen va esser necessi far uniform grammatica, pronunciation e plu sommun paroles. Ma quande lingues coalesce, li grammatica del resultant lingue es plu simplic e regulari quam ti del coalescent lingues.
Section Titles are used to draw attention to specific areas of your content and help guide readers through the page. To make the most of these titles, keep the following best practices in mind.
Eyebrow Background Black
Keep it concise and engagingThe length of your title matters. Aim for short, meaningful phrases that spark interest and clearly reflect the content that follows. A well-crafted title can draw users in and encourage them to explore further.
Eyebrow Background Gold
Be aware of the visual impact
The line beneath the title adjusts to the length of your text. A longer title will create a longer line, which can affect the visual rhythm of your layout. Look for balance to maintain a clean and readable page.
Pennant Background Black
Use action-oriented language when appropriate
Section titles are especially effective when encouraging users to take action, whether it's exploring a topic, signing up, or navigating to another section. Use verbs and active phrasing to prompt engagement.
Pennant Background Boilermaker Gold
FAQ
Q: Can I use more than one Section Title on a page?
A: No. We recommend using just one to maintain clarity and focus.
Q: Should I use Section Titles without any supporting content?
A: No. Section Titles are meant to highlight specific content on a page. Using them without supporting information can confuse readers.